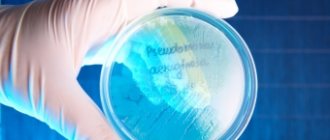

Функции кишечной палочки в организме человека
Бактерии группы кишечной палочки необходимы для жизнедеятельности человека. В этой группе присутствуют различные микроорганизмы, которые называются колиформными бактериями.
Они составляют всего один процент от микрофлоры кишечника и решают ряд важных задач:
- выполняют защитную функцию, препятствуя развитию болезней;
- своим присутствием способствуют размножению бифидо- и лактобактерий;
- участвуют в обмене жиров и холестерина;
- участвуют в выработке витаминов В (всей группы) и K;
- улучшают всасывание соединений с железом и кальцием;
- укрепляют именную систему детей (до 7 лет).
Воздействие полезной кишечной палочки неоценимо в течение всей жизни, но патогенные штаммы этих бактерий провоцируют болезни, вызывают отравления, уничтожают полезную среду кишечника, деструктивно влияют на иммунитет взрослых и детей. В последнем случае это опасно вдвойне, поскольку неокрепший детский организм становится беззащитным к агрессивной внешней среде.
Внимание! Очень опасна кишечная палочка при беременности: инфекция способна проникнуть в плод, развить патологии и привести к выкидышу.Кишечные палочки достаточно устойчивы, они способны выживать некоторое время, даже если покинут организм человека. Это помогает в медицинских исследованиях и лечении, сборе информации при помощи анализа кала, мочи и т.д.
Профилактика кишечной палочки
Все профилактические мероприятия эшерихия коли сводятся к следующим рекомендациям:
- соблюдать правила личной гигиены;
- тщательно мыть овощи и фрукты;
- соблюдать правила термической обработки мяса;
- не пить сырое молоко;
- приобретать мясные и молочные продукты только у проверенных продавцов с сертификатом качества на товар;
- укреплять иммунитет;
- регулярно проводить влажную уборку в доме.
Кишечная инфекция распространена среди взрослых и детей. Она не только сопровождается тяжелой симптоматикой, но и может привести к сильному обезвоживанию, нарушению важных функций организма, а также смерти пациента
Важно соблюдать профилактические меры и лечить кишечную палочку при первых проявлениях
Профилактика заболеваний, спровоцированных кишечной палочкой, заключается в первую очередь в соблюдении общеизвестных гигиенических правил. Не меньшее значение имеет употребление в пищу тщательно промытых овощей и фруктов, безопасной воды и блюд, приготовленных в соответствии с технологическими нормами.
В заключение необходимо еще раз подчеркнуть, что опасности заражения патогенной эшерихией коли подвержены как взрослые, так и дети. И у тех, и у других инфицирование может спровоцировать очень неприятное патологическое состояние. Но оно излечимо. Главное, не заниматься самодеятельностью и не пить антибактериальные препараты без назначения врача.
Соблюдение личной гигиены для профилактики кишечной палочки
Соблюдение личной гигиены: тщательное мытье рук и лица после улицы и многолюдных мест, грамотный подход к интимной гигиене. Контроль чистоты употребляемых сырых продуктов и доведение до нужного состояния молока и мяса. Питье только качественной воды. Использование одежды одноразового использования в больничных учреждениях. Контроль гигиены и состояния здоровья домашних питомцев. Регулярная уборка жилых помещений с использованием надежных, но не агрессивных моющих средств
Осторожность к приемам пищи в заведениях общественного питания и во время отпуска в жарких странах
Бактериальные колонии и их внешний вид
Современные методы исследования позволяют не только разглядеть под микроскопом бактерии и внутреннее строение бактериальной клетки, но и сделать фото и видео этих организмов, как они выглядят. На основании этих данных бактерии разделили на группы, характеризующиеся различной геометрической формой.
- Бактерии округлой формы, или кокки. Выглядят как шарики или овалы, часто имеют жесткую клеточную стенку и окрашиваются по Граму. Рассматривая фото, сделанные под микроскопом, можно обнаружить, что они могут быть одиночными, сдвоенными (диплококки), в виде гроздьев (стафилококки), пакетов по 8 и более клеток или собранными в цепочки различной длины (стрептококки). Среди них много безвредных сапрофитов, живущих на коже и в кишечнике, есть жители горячих источников и ледников, а также симбионты, входящие в состав лишайников. Такие кокки часто окрашены, что хорошо видно при выращивании их колоний на питательной среде. Есть в этой группе и бактерии, способные вызывать нагноения, раневые инфекции, воспаление легких и другие опасные заболевания. Интересно, что колонии сапрофитных кокков обычно ярко окрашены, в то время , как болезнетворные кокки образуют бесцветные колонии.
- Палочковидные бактерии, или бациллы. Выглядят как прямые или изогнутые палочки различной толщины и размеров. В зависимости от места образования спор, различают клостридии (с утолщением с одного конца в виде барабанных палочек) и плектридии, споры которых имеют форму веретена. Так же, как и кокки, бациллы могут объединяться в группы по две клетки (диплобациллы), встречаются также бактерии, образующие длинные цепочки (стрептобациллы). Бациллы могут иметь самые разнообразные виды питания – встречаются сапрофитные формы, живущие на коже, кишечнике, зубах. Среди них наиболее известны кишечные палочки, лактобактерии, возбудители сибирской язвы, чумы, столбняка, газовой гангрены, сальмонеллы. Существуют также свободноживущие бациллы – азотфиксаторы, есть аэробные и анаэробные формы.
- Изогнутые бактерии – спириллы, вибрионы и спирохеты. Часто определяются в моче при наличии инфекций мочеполовой системы. Вторые отличаются подвижностью, а первые – разнообразием изгибов. На фото вибрионы отличаются тем, что их изгиб составляет не более четверти оборота, спириллы имеют 4-6 витков, а еще более изогнутые формы с 7-15 витками называются спирохетами. Видео позволяет сделать вывод, что спирохеты выглядят более подвижными по сравнению с другими изогнутыми бактериями.
- Простекобактерии могут выглядеть как треугольники. На фото эти необычные организмы демонстрируют наличие характерных выростов с острыми концами.
- Микобактерии – бациллы с боковыми выростами.
- Коринебактерии. Палочки с утолщениями на концах и зернами внутри клетки.
- Актиномицеты. Многоклеточные бактерии, состоящие из ветвящихся цепочек, которые выглядят как мицелий грибов. Нити способны фрагментироваться на отдельные клетки (кокки или палочки) или их агрегаты.
Если рассматривать фото, как выглядит человеческая кожа под большим увеличением, или же посеять мазок с кожи на питательную среду, обнаружится, что многие болезнетворные бактерии в небольшом количестве постоянно встречаются на кожных покровах человека.
По сути, количество бактериальных клеток в человеческом организме даже немного больше, чем тех, из которых состоят органы и ткани. Многие из них живут в кишечнике и желудке, заселяют половые органы, встречаются в моче, мокроте и других выделениях. При посевах на питательные среды они образуют колонии, которые выглядят по-разному в зависимости от вида. Аналогичные колонии можно наблюдать и в природе – например, у синезеленых водорослей, актиномицетов и архей.
Фото колоний одного и того же вида бактерий могут выглядеть по-разному в зависимости от условий выращивания, наличия в питательной среде витаминов, минералов, ее плотности. Колонии могут выглядеть крупными (диаметр более 4-6 мм), средними (2-4 мм в диаметре) и мелкими, иметь округлую, овальную, ветвящуюся (ризоидную), розеточную форму, отличаться прозрачностью или цветом, рельефом, консистенцией.
Например, спириллы хеликобактер пилори при их определении в кишечнике или в моче у женщин методом посевов смыва фекалий на плотных средах образуют прозрачные, блестящие колонии небольшого размера, а в жидких – тонкие серовато-голубые пленки и выглядят как небольшое помутнение жидкости. Сероперерабатывающие образуют колонии в виде цветных слизей на камнях водоемов и источников, а азотфиксирующие актиномицеты похожи на мелкие нитевидные корешки, практически незаметные в корневой системе растения.
При определении бактерий в моче человека чаще других встречаются кишечная палочка, лактобактерии, протеи, клебсиелла, энтерококк. Внешний вид их колоний позволяет визуально оценить наличие бактерий в моче и определить их чувствительность к антибиотикам. Для дифференциальной диагностики бактерий в моче в среды можно добавлять специфичные антибиотики или питательные вещества, позволяющие выделить чистые культуры бактерий одного вида.
Работаю врачом ветеринарной медицины. Увлекаюсь бальными танцами, спортом и йогой. В приоритет ставлю личностное развитие и освоение духовных практик. Любимые темы: ветеринария, биология, строительство, ремонт, путешествия. Табу: юриспруденция, политика, IT-технологии и компьютерные игры.
Кишечная палочка в норме
В нормальных условиях кишечная палочка заселяет кишечник человека (безопасные ее штаммы), среднее количество варьирует от 106 до 108 КОЕ/г содержимого дистального отдела кишечника (КОЕ – колониеобразующая единица). Содержание E.coli в составе другой микрофлоры кишечника не более 1%. В обычных условиях кишечная палочка принимают участие в нормальном функционировании кишечника, синтезирует витамины К, В1, В2, В3, В5, В6, В9, B12.
Непатогенный штамм Nissle 1917 (Mutaflor) применяется с лечебной целью у детей в качестве пробиотика при дисбактериозе кишечника. В кишечнике более полезны так называемые лактозопозитивные кишечные палочки, содержание лактозонегативных не должно превышать 105 КОЕ/г, а гемолитические E. coli и вовсе должны отсутствовать.
Качественный и количественный состав E.coli толстого кишечника у здоровых людей разных возрастов, как у детей до года, так и старше 60 лет, не имеет различий. Для типичных E.coli это 107-108 КОЕ/г фекалий, E.coli лактозонегативные {amp}lt; 105, гемолитические кишечные палочки в норме отсутствуют. Состав остальной флоры кишечника отличается по возрастам по другим параметрам.
Отклонения в содержании непатогенных штаммов кишечной палочки в кишечнике называются дисбактериозом и имеют несколько степеней.
Степени микробиологических нарушений E. coli при дисбактериозе кишечника
- 1-я степень микробиологических нарушений: типичных эшерихий до 106-105 КОЕ/г, возможно повышение содержания типичных эшерихий до 109- 1010 КОЕ/г.
- 2-я степень микробиологических нарушений: повышение содержания гемолитических эшерихий до концентрации 105-107 КОЕ/ г.
- 3-я степень микробиологических нарушений: обнаружение E.coli в ассоциации с другими условнопатоген-ными микроорганизмами в концентрации 106-107 КОЕ/г и выше.
Модельный организм
E. coli
часто используют в качестве модельного организма в микробиологических исследованиях. Культивируемые штаммы, например,
E. coli
K12 хорошо приспособлены к росту в лабораторных условиях, и, в отличие от штаммов дикого типа, неспособны заселять кишечник. Многие лабораторные штаммы утеряли способность образовывать биологические плёнки[24][25]. Описанные особенности предохраняют штаммы дикого типа от антител и химических агентов, но требуют больших затрат вещества и энергии.
В 1946 году Джошуа Ледерберг и Эдуард Тейтем описали явление конъюгации бактерий, используя кишечную палочку в качестве модельного организма[26]. E. coli
остаётся одной из наиболее востребованных бактерий при изучении конъюгации и в настоящее время.
E. coli
была важным компонентом первых экспериментов по генетике бактериофагов[27], ранние исследователи, например, Сеймор Бензер, использовали
E. coli
и фаг T4 для изучения структуры генов[28]. До исследований Бензера не было известно, имеет ген линейную или разветвлённую структуру.
Кишечная палочка E. coli
была одним из первых организмов, чей геном был полностью секвенирован. Последовательность нуклеотидов в геноме штамма К12
E. coli
была опубликована в журнале
Science
в 1997 году[29].
Долговременный эксперимент по эволюции E. coli
был начат Ричардом Ленски в 1988 году и позволил непосредственно наблюдать эволюционные изменения в лабораторных условиях[30]. В данном эксперименте одна популяция
E. coli
получила возможность аэробно метаболизировать цитрат. Такая способность встречается у
E. coli
в норме крайне редко. Неспособность к росту в аэробных условиях используют для того, чтобы отличить
E. coli
от других родственных бактерий, например,
Salmonella
. В ходе данного эксперимента в лабораторных условиях удалось наблюдать процесс видообразования.
Кислотоустойчивые бактерии и гастрит
Длительное время считалось, что повышенная кислотность в желудке предохраняет его от проникновения бактерий. Это заблуждение опровергло открытие возбудителя гастрита и язвы желудка – бактерии хеликобактер (Helicobacter pylori). Клетки этих бактерий по своей форме выглядят как грамотрицательные спириллы.
Старые культуры хеликобактер полны клеток, выглядящих как кокки, – эти клетки помогают культуре переживать неблагоприятные условия. Кокки бактерий рода хеликобактер также способны селиться на внутренних стенках пищеварительного тракта, встречаются в природных источниках, однако в культурах они расти не могут.
Патогенные кишечные палочки
Выделяют более 100 штаммов патогенной кишечной палочки, которые объединены в 4 класса:
- энтеропатогенные E. Coli (ETEC);
- энтеротоксигенные E. coli;
- энтероинвазивные E.coli (EIEC);
- энтерогеморрагические E.coli (EHEC).
Морфологически они ничем не отличаются. Особенностью патогенных штаммов является способность при попадании в организм человека продуцировать энтеротоксины (термостабильные или стойкие к высоким температурам и термолабильные или быстроразрушающиеся), за счет которых возникает диарея. Например, E.coli O157:H7, которая продуцирует подобные токсины.
Помимо этого для каждой группы характерны свои особенности симптомов заболевания.
Что такое кишечная палочка?
Кишечная палочка (Escherichia coli) — бактерии, относящиеся к роду Escherichia и семейству Enterobacteriaceae. Эти микроорганизмы обладают высокой устойчивостью, они способны жить месяцами в воде, почве, фекалиях.
Группа заболеваний, связанных с кишечной палочкой и вызываемые патогенными штаммами бактерии, называется эшерихиозы. Выступают как причины возникновения заболевания кишечника, почек и других органов. Это создает ряд проблем в области пищеварения, мочеполовой системы.
Бактерии быстро и хорошо размножаются в продуктах питания, особенно в молоке, а потому съедание зараженных и обсемененных кишечной палочкой блюд вызывает заражение с последующим развитием инфекционно-воспалительного заболевания.
Как можно заразиться?
Кишечная палочка передается в основном орально-фекальным или, реже, контактно-бытовым путем.
При орально-фекальном пути передачи кишечная палочка с каловыми массами попадает в воду или почву, а также на сельскохозяйственные растения. Далее инфицирование может происходить различными путями, например, при заглатывании грязной воды бактерии попадают в организм и приводят к развитию кишечных инфекций.
Контактно-бытовой путь распространения кишечных палочек встречается реже и играет наибольшее значение для развития вспышек эшерихиозов в коллективах, например, в больницах, родильных домах, детских садах, школах, в семьях и т.д. При контактно-бытовом пути кишечные палочки могут передаваться от матери к новорожденному ребенку при прохождении последнего по родовым путям, загрязненным бактериями.
Причины патологии
Основной причиной появления кишечной палочки является нарушение микрофлоры кишечника. Именно поэтому размножается патогенный серотип кишечной палочки. Причиной ее возникновения достаточно часто являются разнообразные болезни пищеварительного тракта. Достаточно часто патологический процесс диагностируется на фоне панкреатитов, которыми поражается поджелудочная железа.
Этими традиционными медикаментами производится подавление микроорганизмов, которыми устраняется возможность появления патогенной микрофлоры. Прием антибактериальных препаратов достаточно часто приводит к возникновению патологии. Человек может заражаться патогенными штаммами фекалльно-оральным путем.
Развивается патология при несоблюдении человеком правил гигиены в период приготовления еды. Если пациент употребляет в пищу немытые овощи и фрукты, то это зачастую приводит к возникновению кишечной палочки. При поливе растений грязной сточной водой после их употребления в пищу может появляться кишечная палочка.
Также причиной ее появления является употребление в пищу сырого молока или плохо прожаренного мяса. Кишечная палочка в большинстве случаев появляется из-за неправильного образа жизни человека. Именно поэтому пациентам рекомендуется внимательно относиться к своему здоровью.
Правила лечения
Кроме приема антибиотиков больному необходимо выполнять определенные правила лечения.
Если у пациента наблюдается понос или рвота, то ему необходимо в обязательном порядке пить регидрационные растворы.
С их помощью осуществляется восполнение потерянной жидкости и соли.
При каждом опорожнении кишечника и рвоте необходимо выпивать от 300 до 600 миллилитров регидрационного раствора.
Для его приготовления может использоваться аптечный порошок в виде Трисоля, Регидрона, Глюкосолана.
Также для приготовления раствора можно использовать пищевую соду, соль и сахар. При покупке традиционных медикаментов их необходимо просто развести в воде в соответствии с инструкцией производителя.
Для приготовления домашнего регидрационного раствора необходимо взять литр чистой воды и добавить в него столовую ложку сахара. Также необходимо добавить пищевую соду и соль по 0.5 столовых ложек. При отсутствии в доме регидрационного раствора пациенту рекомендуется питье любых напитков.
Достаточно эффективными являются компоты, морсы, чаи с сахаром. Для обеспечения максимально качественного лечения инфекционных болезней, которые возникают при появлении кишечной палочки, рекомендуется прием энтеросорбентов:
Для обеспечения комплексного лечения болезни рекомендуется применение пробиотиков – Баактисубтила, Энтерола, Бифидумбактерина. Если у пациента наблюдается повышение температуры тела более 38 градусов, то ему рекомендуется применение жаропонижающих аптечных лекарств, основой которых является ибупрофен, нимесулид, парацетамол.
С помощью традиционных медикаментов можно устранить не только симптоматику заболевания, но и уничтожить кишечную палочку в организме человека.
Какие заболевания вызывает инфекция?
Поскольку палочки чаще всего попадают именно в желудочно-кишечных тракт, соответственно они вызывают болезни ЖКТ, а также кишечные инфекции (эшерихиозы), которые сопровождаются симптоматикой интоксикации.
Могут возникнуть такие заболевания:
- энтерит и геморрагический колит;
- воспаление влагалища, матки и придатков;
- простатит, орхит, эпидидимит у мужчин;
- кольпит, вульвовагинит;
- воспаление почек и мочевого пузыря;
- уретрит;
- отит;
- неврит.
Конкретные симптомы кишечной палочки зависят от штамма.
Кишечная палочка: симптомы и признаки
В практической деятельности врачей инфекционного профиля применяются как этиопатогинетические, так и клинические классификации кишечной палочки. Разделение кишечной палочки по клиническому принципу заключается в вынесении в диагноз основного клинического симптомокомплекса, например, «гастроэнтерическая кишечная палочка». Кроме того, обязательно необходимо указывать тяжесть течения кишечной палочки, которая может варьировать в широких пределах.
Энтеротоксическая кишечная палочка является провокатором развития яркой клинической симптоматики у детей. Для данного типа возбудителя характерен короткий период инкубации, по окончанию которого развивается выраженный интоксикационный и диспепсический синдром, а также дисфункция кишечника. Опасность кишечной палочки в этой ситуации заключается в склонности к быстрому развитию дегидратации детского организма, а также генерализованного сепсиса, при котором прогноз в отношении выздоровления минимален.
При холероподобном варианте течения кишечной палочки отмечается короткий период инкубации возбудителя и умеренно-выраженные признаки интоксикации. Более характерными для данного варианта клинического течения симптомами является выраженный болевой синдром в брюшной полости, нарушение деятельности кишечника и нарастающий дегидратационный синдром.
В случае попадания в организм человека кишечной палочки гемолитического типа отмечается развитие клинической картины катарально-геморрагического колита. Продолжительность активной клинической симптоматики в этой ситуации составляет около одной недели, однако, при осложненном варианте течения может наблюдаться развитие гемолитико-уремического синдрома.
Кишечная палочка при беременности
У беременных женщин в мазке из влагалища и в моче часто выявляют кишечную палочку. Причем многие женщины говорят, что до беременности бактерию никогда не находили в анализах. Это не означает, что женщина заразилась во время беременности. Напротив, выявление эшерихии коли свидетельствует о том, что женщина давно является носительницей кишечной палочки, просто во время беременности ее иммунная система больше не может подавлять активность данного микроба, вследствие чего он размножился настолько, что его смогли обнаружить в анализах.
Появление бактерии не означает, что женщина обязательно больна, но свидетельствует о том, что ее половые пути или мочевыводящая система обсеменена кишечными палочками, способными спровоцировать воспалительный процесс в любой момент. Поэтому даже при отсутствии симптомов заболевания врачи-гинекологи, ведущие беременность, назначают антибиотики для уничтожения бактерии.
Ведь если кишечная палочка останется в моче, то рано или поздно это приведет к появлению у беременной женщины пиелонефрита или цистита. Если же кишечная палочка останется во влагалище, то это может привести к кольпиту, который, как известно, способен спровоцировать преждевременное излитие околоплодных вод.
Кроме того, наличие кишечной палочки во влагалище перед родами представляет собой опасность для плода, поскольку ребенок может инфицироваться микробом во время прохождения по родовым путям матери. А такое инфицирование младенца может привести к развитию тяжелых заболеваний, таких, как сепсис, менингит, отит или кишечная инфекция, которые для новорожденного смертельно опасны.
Таким образом, очевидно, что обнаружение кишечной палочки в мазке из влагалища или в моче у беременной женщины требует обязательного лечения, даже если отсутствуют какие-либо симптомы воспалительного процесса в почках, мочевом пузыре, уретре или влагалище.
Симптомы и разновидности инфекции, вызванной кишечной палочкой (коли-инфекции)
Инкубационный период (от момента заражения до появления симптомов) при коли-инфекции длится 1-6 дней; как правило 3 дня.
Различают кишечную коли-инфекцию, паракишечную коли-инфекцию и септическую коли-инфекцию.
Кишечная коли-инфекция
Кишечная коли-инфекция протекает с преимущественным поражением тонкой или толстой кишки. Инкубационный период в обоих случаях до 3 суток, но при поражении толстой кишки немного короче.
Вот симптомы преимущественного поражения тонкой кишки:
- острое начало;
- слабость, головокружение, в половине случаев повышение температуры тела до 37,5-38,0 градусов;
- в ⅓ случаев тошнота и рвота;
- схваткообразные боли по всему животу; вздутие и урчание живота;
- частый жидкий стул, из которого в течение нескольких часов исчезают примеси кала; зловонного запаха нет.
Теперь симптомы преимущественного поражения толстой кишки:
- у 60% пациентов острое начало: озноб, резкая слабость, головная боль;
- у ¾ пациентов повышение температуры тела до 38 градусов; у остальных — до 39-40 градусов;
- водянистый понос, длящийся до 8 часов;
- симптомы колита, которые сменяют водянистый понос: боль в нижней части живота с ложными позывами на дефекацию; кашицеобразный стул со слизью и прожилками крови до 10 раз в сутки.
Паракишечная коли-инфекция
Непатогенные для кишечника штаммы кишечной палочки при попадании в другие органы и полости могут вызвать болезни, объединенные в понятие “Паракишечная коли-инфекция”. Приводим самые распространенные из них:
- перитонит, если кишечная палочка попадает в брюшную полость через поврежденную стенку желудка и кишечника, например, при язвенной болезни желудка и двенадцатиперстной кишки, прободном аппендиците, колите, болезни Крона, пр.;
- пиелонефрит, уретрит — когда инфекция проникает в мочевыводящие пути;
- воспаление слизистой влагалища (кольпит) — при попадании кишечной палочки во влагалище;
- пневмония, если коли-инфекция попадает в легкие;
- менингит — в результате проникновения инфекции в мозговые оболочки.
Септическая коли-инфекция
Чаще всего возникает у новорожденных и недоношенных детей. Кишечные проявления — понос и спастические боли, как правило, не выражены. Преобладают симптомы тяжелой интоксикации, высокая лихорадка, рвота, анорексия. Формируются гнойные очаги во внутренних органах.
Кишечная палочка у грудничка
У грудничков в каловых массах при анализе на дисбактериоз или копрограмме (копрологии) часто обнаруживают кишечные палочки двух видов – гемолитическую и лактозонегативную. В принципе, гемолитической кишечной палочки в каловых массах ни грудничка, ни взрослого человека быть не должно, поскольку она является чисто патогенным микробом и вызывает кишечные инфекции, протекающие по типу геморрагического колита.
Однако при обнаружении гемолитической кишечной палочки у грудничка не стоит спешить начинать лечение антибиотиками. Чтобы понять, нужно ли лечить малыша, следует объективно оценить его состояние. Так, если ребенок нормально прибавляет вес, развивается, хорошо кушает и не страдает от водянистого стула желтого цвета, выходящего из ануса ребенка буквально струей, то лечить малыша не нужно, поскольку терапия необходима только при наличии симптоматики, а не цифр в анализах.
Лактозонегативная кишечная палочка в фекалиях грудничка вполне может присутствовать, поскольку она является компонентом нормальной микрофлоры, и в норме может составлять до 5% от общего количества всех эшерихий коли, имеющихся в кишечнике. Поэтому обнаружение лактозонегативной кишечной палочки в кале грудничка неопасно, даже если ее количество превышает нормы, указываемые лабораторией, при условии, что ребенок нормально набирает вес и развивается.
Диагностика
При возникновении кишечной инфекции важнейшее значение имеет метод диагностирования заболевания, который поможет определить конкретный вид бактерии, найти правильный способ лечения и предпринять своевременные действия.
- Метод бактериологического исследования, который проводится с помощью посева различных материалов:
- если пострадал кишечник, анализируют кал или рвоту;
- при поражении мочевых путей, анализируют мочу;
- в случае инфицирования половых органов, берется мазок или соскоб со слизистой.
Материалы помещаются в специальные среды, в которых микроорганизмы размножаются; затем они проверяются на чувствительность к антибиотикам. Это помогает врачу назначить самые эффективные лекарства для лечения.
- Метод исследования с помощью специальных медицинских препаратов предполагает использование ультразвука, урографии и др.
- Метод общих клинических исследований широко распространен. Он не позволяет обнаружить патогенные бактерии, но может подтвердить наличие воспаления в кале, моче, гное или крови. Применяется в качестве дополнительного метода диагностирования.
В мочеполовую систему микроорганизмы возникают при анальном сексе и несоблюдении элементарных правил гигиены. Бактерии попадают в мочевые пути из кишечника, закрепляются в них и полностью не вымываются при мочеиспускании.
Бактерии группы кишечной палочки при их нахождении в мочи не являются признаком наличия инфекции. Это может быть проявлением патологических изменений в мочевыводящей системе.
Кишечная палочка в мазке у женщин является следствием:
- ношения тесного нижнего белья;
- незащищенного анального секса;
- несоблюдении правил гигиены.
Во время беременности наличие патогенных бактерий рискованно для ребенка. Кишечная палочка во влагалище способна перейти к ребенку при родах и вызвать менингит.
Кишечная палочка в моче и мазках
При несоблюдении правил личной гигиены, а также во время полового акта кишечная палочка способна проникать во влагалище. В дальнейшем этот микроорганизм провоцирует развитие вагинита и кольпита, а при снижении иммунитета бактерия способна проникнуть в мочевые органы и вызвать их воспаление (цистит, пиелонефрит).
Для диагностирования заболеваний органов мочеполовой системы необходимо произвести бак исследование мочи. Однако наличие кишечных палочек в моче не всегда говорит о наличии заболевания. Бактерии, обнаруженные в малом количестве, могут означать, что женщина перед сдачей анализа не произвела должные гигиенические процедуры.
У мужчин именно кишечная палочка часто является причиной простатита, орхита или эпидидимита.
Кишечная палочка, как возбудитель заболеваний мочеполовой системы
В норме кишечная палочка в моче обнаруживаться не должна, но если при сдаче анализов она была там найдена, врач должен в срочном порядке заняться ее лечением. Обычно этот микроорганизм обнаруживается врачами-гинекологами при осмотре беременных женщин, причем для многих наличие этого микроорганизма в микрофлоре влагалища становится сюрпризом. Обнаруженная кишечная палочка в мазке свидетельствует о начале развития воспалительного процесса одного или нескольких органов мочеполовой системы (существует вероятность того, что бактерия передается половым путем от одного партнера к другому).
Нужно сказать о том, что кишечная палочка во влагалище, должна стать поводом к тому, чтоб из лаборатории, сразу же отправиться в кабинет к врачу. Дело в том, что она существенно ослабляет местный иммунитет и делает организм больного человека практически беззащитным перед другими опасными бактериями, например, перед протеусом или стафилококком, что в итоге может стать причиной развития гонореи или хламидиоза, следовательно, лечить это состояние должен только специалист.
Гонорея у женщин
Гемолизирующая кишечная палочка является причиной развития 80% заболеваний мочеполовой системы, к которым относится:
- острый и хронический простатит у мужчин (кишечная палочка в мазке при диагностике простатита обнаруживается практически в 65% случаев);
- воспаление яичников и придатков у женщин;
- цистит;
- вагинит (если кишечная палочка в мазке на вагинит обнаруживается сразу, то лечение этого недуга проходит максимально быстро, а отсутствие адекватной терапии может стать причиной развития серьезных проблем со здоровьем);
- пиелонефрит (очень часто гемолизирующая кишечная палочка обнаруживается при диагностике пиелонефрита у беременных);
- кольпит и так далее.
На самом деле в гинекологии гемолизирующая кишечная палочка занимает особенное место, потому что при попадании во влагалище она провоцирует развитие ряда таких заболеваний, которые впоследствии приводят к бесплодию и трудно поддаются лечению. По этой причине врачи советуют делать профилактику и диагностику этого возбудителя (определяется кишечная палочка в мазке) хотя бы один раз в год.
Как лечить кишечную палочку?
Лечение кишечных инфекций, вызванных палочкой, обычно комплексное и включает в себя следующие пункты:
- Антибиотики. Антибактериальная терапия составляет основу лечения кишечной палочки. Тот или иной препарат назначается после определения чувствительности к нему микроорганизмов. Чаще всего рекомендуют антибиотики группы цефалоспоринов: Цефелим, Цефалексин, Левофлоксацин. Препараты принимаются курсами по 5-10 дней. Курс нельзя прерывать или превышать дозировку без разрешения врача.
- Бактериофаги. Это препараты, уничтожающие бактерии более мягко и безопасно, чем антибиотики, но они бывают эффективны не всегда. По сути бактериофаги представляют собой вирусы, которые живут и размножаются только при наличии определенных бактерий. Эти вирусы существуют за счет бактерий, уничтожая их. К бактериофагам относят Секстафаг, Интести-бактериофаг и т.д.
- Обезболивающие препараты. Если боли в животе сильные, назначаются обезболивающие препараты типа Но-шпа, Брал, Спазмалин, Нурофен. Однако их нельзя принимать длительное время.
- Пробиотики. Пробиотики (Линекс, Бифидумбактерин и т.д.) помогают восстановить нормальный баланс патогенных и полезных микроорганизмов в кишечнике.
Лечение и дозировку препаратов должен прописывать врач. Самолечение может быть опасным, особенно во время беременности или в раннем возрасте.
Как лечить?
Лечить кишечную палочку должен врач, который вначале делает бактериальный посев и точно определяет штамм возбудителя. Интенсивность и длительность лекарственной терапии зависит от вида бактерии, ее локализации и индивидуальных особенностей организма больного человека. В процессе лечения важную роль играет диета и прием пробиотиков – препаратов, нормализующих кишечную микрофлору. После окончания курса лекарственной терапии все анализы сдаются повторно.
Что делать?
Если Вы считаете, что у вас Кишечная палочка
и характерные для этого заболевания симптомы, то вам могут помочь врачи: инфекционист, гинеколог, гастроэнтеролог.
Источник
Понравилась статья? Поделись с друзьями в соц.сетях:
Последствия
Escherichia coli может вызывать заболевания и в других органах, помимо кишечника. В мочевыводящих путях эта бактерия способна также вызвать воспаление. У девушек и женщин этот риск является более высоким, чем у мужчин, т.к. у них имеется короткий путь из кишечника в уретру.
Кроме того, бактерия нередко является виновником респираторных инфекций, причиной неонатального менингита (воспаление головного мозга) и др. Эти условия относятся, в основном, к слабым и долгосрочно прикованным к постели людям.
Лечение кишечных инфекций часто заключается только в пополнении жидкости, диете и добавке подходящих бактерий, которые предотвращают размножение кишечной палочки. Было установлено, что антибиотики повышают секрецию токсина из бактерий, так что, иногда трудно сделать выбор в пользу конкретного варианта лечения. В случае воспалений других органов и тканей, лечение всегда предполагает использование антибиотических препаратов.
Симптомы кишечной палочки
Симптомы заражения кишечной палочкой проявляются по-разному, поэтому каждый класс патогенных бактерий необходимо рассматривать в отдельности. Состояние здоровья зараженного человека будет зависеть от того, в какую группу относятся и с какой скоростью размножаются кишечные палочки, симптомы заболеваний описаны ниже.
К общим признакам развития в организме патогенных кишечных палочек относятся такие симптомы, как:
- Нарушение пищеварительного процесса;
- Боли в зоне живота;
- Рвота и тошнота;
- Проявления метеоризма;
- Неприятный запах, ощущаемый изо рта;
- Слабость;
- Сонливость;
- Потеря аппетита;
- Повышенная температура тела;
- Падение артериального давления.
В зависимости от вида бактерий человек замечает у себя присутствие тех или иных признаков.
Симптомы в зависимости от вида бактерии
Эшерихиоз, вызванный энтероинвазивными палочками, вызывает поражение толстого отдела кишечника. Развивается заболевания с возникновения общеинтоксикационных симптомов:
- слабости,
- головной боли,
- озноба,
- повышения температуры.
Спустя несколько часов возникают схваткообразные боли внизу живота.
- Возникает диарея, стул сначала водянистый и обильный. Но по мере поражения толстой кишки развивается колит.
- Симптомами этого состояния являются частый жидкий или кашицеобразный стул с примесью слизи, прожилками крови.
Этот вариант эшерихиоза характеризуется доброкачественным течением. Температура и стул нормализуются уже спустя один-три дня.
Кишечные инфекции, вызванные энтеропатогенными кишечными палочками, у взрослых и детей старше 3 лет протекают по типу сальмонеллеза. То есть заболевание начинается остро:
- появляется тошнота,
- рвота,
- боли в животе,
- умеренно или незначительно повышается температура тела.
Стул становится жидким, водянистым и обильным, причем больной ходит в туалет по 2–6 раз в сутки. При дефекации испражнения буквально брызжут. Инфекция в среднем продолжается в течение 3 – 6 дней, после чего наступает выздоровление.
Энтеротоксигенные кишечные палочки опасны тем, что могут прикрепляться именно к слизистой оболочке кишечника, чем существенно нарушают его работу. Инфекция передается через немытые руки или фрукты, поэтому симптомы жизнедеятельности кишечных бактерий в человеческом организме иногда называют «диареей путешественника», которая сопровождается:
- водянистым поносом без крови,
- тошнотой,
- приступообразной болью в животе.
Проявления заражением энтерогеморрагической инфекции:
- Некроз;
- Присутствие кровяных сгустков (в кале);
- Перитонит;
- Диарея (водянистый стул).
Симптомы инфекции у ребенка отличаются более тяжелым течением, особенно при поражении новорожденных или детей, имеющих низкую массу тела.
Escherichia coli может вызывать заболевания и в других органах, помимо кишечника. В мочевыводящих путях эта бактерия способна также вызвать воспаление. У девушек и женщин этот риск является более высоким, чем у мужчин, т.к. у них имеется короткий путь из кишечника в уретру.